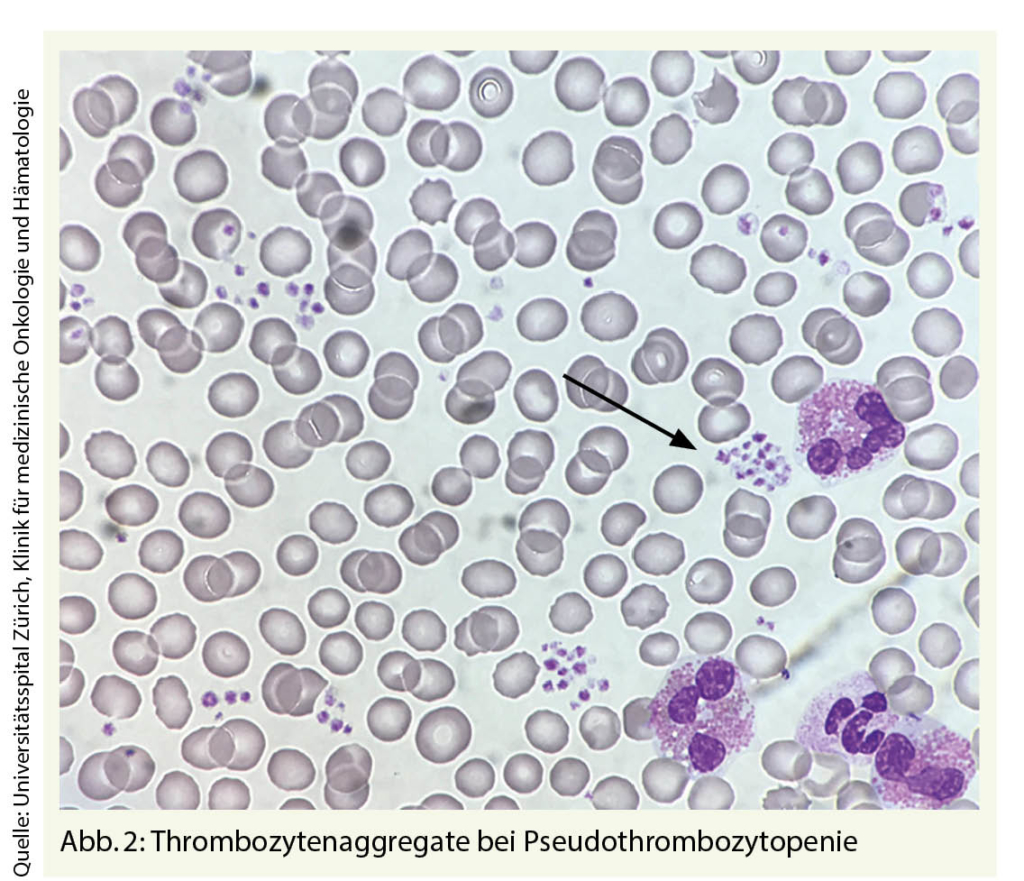

- Unklare Thrombozytopenie
In jeder medizinischen Disziplin können wir mit einer Thrombozytopenie konfrontiert werden. Dabei kann es sich um einen Zufallsbefund ohne Krankheitswert, aber auch um einen lebensbedrohlichen Notfall handeln. Dieser Artikel sollte bei der Einschätzung und Zuordnung von Thrombozytopenien helfen.
Der Normbereich für Thrombozyten weist mit 150 – 450 G/l eine hohe Streubreite auf. Frauen weisen durchschnittlich höhere Werte auf als Männer und Patienten mit schwarzer Hautfarbe höhere Werte als Weisse (1). Intraindividuell besteht hingegen eine höhere Konstanz (2). In der Schwangerschaft kommt es zu einem physiologischen Abfall der Thrombozyten bis zum Nadir am Geburtstermin. Mehrheitlich liegen die Werte dabei im unteren Normbereich, in ca. 10% der Schwangerschaften fallen die Thrombozyten unter 150 G/l. Gestations-Thrombozytopenien < 100 G/l sind selten und sollten Anlass zur weiteren Abklärung geben (3).
Wie äussert sich eine Thrombozytopenie?
Leitsymptom der Thrombozytopenie sind Haut- und Schleimhaut-
einblutungen (Petechien, Hämatome, Zahnfleischblutung, Menorrhagie, Epistaxis). Weichteil- und Gelenkeinblutungen sind in der Regel durch eine Verminderung der Gerinnungsfaktoren (z.B. Hämophilie, Antikoagulantien) bedingt. Eine Blutungsneigung ist bei sonst Gesunden ohne blutverdünnende Medikation erst bei Thrombozyten < 100 G/l zu erwarten. Bei Thrombozyten < 50 G/l kommt es zu verstärkten Blutungen bei Verletzungen und Operationen, Werte zwischen 10 und 30 G/l führen zu Petechien und Schleimhautblutungen. Bei Thrombozyten < 10 G/l können Spontanblutungen auftreten. Eine gestörte Thrombozytenbildung führt bei gleichem Thrombozytenwert zu einer stärkeren Blutungsneigung als ein gesteigerter Thrombozytenverbrauch oder ein Hypersplenismus (Tab. 1).
Welche Fragen führen weiter?
Anamnestisch ist die Einnahme von Medikamenten zu erheben, die eine Thrombozytopenie verursachen können. Nebst Heparin sind dies vor allem Antibiotika wie Sulfonamide, Penicilline, Cephalosporine, Vancomycin und Antiepileptika. Thrombozytopenien entwickeln sich hierbei innerhalb von 1-2 Wochen nach Einnahme (bei Vorexposition auch nach wenigen Stunden) und sollten sich innerhalb einer Woche nach Sistieren des Medikamentes erholen (4). Des Weiteren zu erfragen ist ein Alkoholkonsum, welcher ab Tagesmengen von 80 g/l direkt knochenmarktoxisch ist oder via Hepatopathie oder einen Hypersplenismus zu einer Thrombozytopenie führen kann. Eine HIV- oder Hepatitis C-Risikoexposition und Symptome, die auf einen viralen Infekt (z.B. EBV, Parvovirus, Varizellen) hindeuten, lassen eine infektiös bedingte Thrombozytopenie vermuten. B-Symptome (Gewichtsverlust, Nachtschweiss, Fieber) deuten auf ein zu Grunde liegendes Malignom hin. Im seltenen Fall einer Thromboseneigung muss an eine Heparin-induzierte Thrombozytopenie (HIT), ein Antiphospholipidsyndrom, eine disseminierte intravasale Koagulopathie (DIC), eine paroxysmale nächtliche Hämoglobinurie (PNH) oder aber eine thrombotische Mikroangiopathie (z.B. TTP/HUS) gedacht werden. Eine familiäre Blutungsneigung kann auf eine kongenitale Ursache (z.B. Bernard-Soulier-Syndrom) hinweisen, welche – wenn erst im Erwachsenenalter erfasst – meist als ITP fehlinterpretiert wird.
Welche Untersuchungen nehme ich vor?
In der Abbildung 1 ist eine Flowchart zur Abklärung einer Thrombozytopenie dargestellt. Petechien sind häufigstes klinisches Zeichen einer Thrombozytopenie, Hämatome können ebenfalls auftreten. Lymphadenopathien deuten auf eine hämatologische oder infektiologische Grunderkrankung hin, Hepato- und Splenomegalie können zusätzlich auf eine Hepatopathie hinweisen.
Labordiagnostisch sollte bei asymptomatischen Patienten mit isolierter Thrombozytopenie eine EDTA-Pseudothrombozytopenie ausgeschlossen werden. Hierbei handelt es sich um ein in vitro Phänomen, bei dem es im mit EDTA-antikoagulierten Blutröhrchen zur Bildung von Thrombozytenaggregaten kommt, die maschinell nicht erkannt werden. Passend dazu finden sich im Blutausstrich gruppierte Thrombozyten (Abb. 2.)
Dieses Phänomen wird in 0,1% der Blutproben beobachtet und ist klinisch bedeutungslos. Die Analyse in Heparin- oder Citratblut lässt die Pseudothrombozytopenie von der echten Thrombozytopenie unterscheiden. Das mikroskopische Blutbild liefert Hinweise für eine Mikroangiopathie (Fragmentozyten), eine Leukämie (Blasten), ein Lymphom, ein MDS (Dysplasien) oder eine hereditäre Thrombozytopenie (grosse Thrombozyten).
Kreatinin, LDH, CRP, Bilirubin, AST/ALT, ANA, HIV-, HCV- und EBV-Screening, INR, aPTT, Fibrinogen sollten je nach klinischem Kontext erhoben werden. Eine Knochenmarkuntersuchung kann weiterhelfen bei unklarer Ätiologie und bei Verdacht auf eine primäre hämatologische Erkrankung.
Bleibt eine isolierte Thrombozytopenie < 100 G/l trotz umfassender Untersuchung unklar, besteht der Verdacht auf eine primäre Immunthrombozytopenie (ITP). Diese wird verursacht durch eine Autoimmunreaktion gegen Thrombozyten und Megakaryozyten (5). Die ITP ist eine Ausschlussdiagnose, da dafür kein pathognomonischer Test existiert. Bei typischen Befunden kann eine Knochenmarkpunktion entfallen. Die Therapie richtet sich nach Ausprägung und Symptomatik und besteht in der Erstlinie aus Steroiden. Bei steroidrefraktären Fällen stehen Thrombopoietin-Rezeptor-Agonisten (Eltrombopag, Romiplostim), der CD20-Antikörper Rituximab und die Splenektomie zur Verfügung.
Wann ist unverzügliches Handeln geboten?
Die Mehrzahl der leichten, ambulant diagnostizierten Thrombozytopenien verlaufen gutartig und sind durch Infektionen oder Medikamentennebenwirkungen erklärt. In jedem Fall empfiehlt sich eine kurzfristige Nachkontrolle, um einen weiteren Abfall nicht zu verpassen. Notfälle sind – nebst Blutungen bei schwerer Thrombozytopenie – die thrombotische Mikroangiopathie (TTP-HUS), Leukämien, Lymphome und die Heparin-induzierten Thrombozytopenien (HIT). In diesen Fällen sollte umgehend ein Spezialist konsultiert werden.
Zu den thrombotischen Mikroangiopathien gehören das Hämolytisch-Urämische Syndrom (HUS), häufig nach blutiger Enteritis mit E. coli, und die Thrombotische Thrombozytopene Purpura (TTP). Diese Erkrankungen gehen oft mit einer Coombs-negativen hämolytischen Anämie (LDH und Bilirubin erhöht) und einer Niereninsuffizienz einher. Gelegentlich bestehen Fieber und neurologische Symptome (Verwirrtheit, fokale neurologische Ausfälle, Krampfanfälle). Da die Prognose unbehandelt infaust ist, sollte eine unverzügliche Zuweisung an ein Zentrumsspital erfolgen.
Tritt die Thrombozytopenie nach Exposition mit Heparin auf, ist die Wahrscheinlichkeit einer Heparin induzierten Thrombozytopenie (HIT) mit dem 4T-Score abzuschätzen (6). Bei mittlerer bis hoher Vortest-Wahrscheinlichkeit empfehlen wir die Kontaktaufnahme mit einem Hämatologen und die Bestimmung der HIT-Antikörper.
Bei einer lebensbedrohlichen Blutung im Rahmen einer ITP sind nebst Steroiden intravenöse Immunglobuline und Thrombozyten zu verabreichen.
Klinik für Medizinische Onkologie und Hämatologie
Universitätsspital Zürich
Rämistrasse 100
8091 Zürich
Zentrum für Hämatologie und Onkologie
UniversitätsSpital Zürich
Rämistrasse 100
8091 Zürich
Die Autorinnen haben in Zusammenhang mit diesem Artikel keine Interessenskonflikte deklariert.
- Thrombozytenwerte zeigen interindividuell eine starke Streubreite, sind intraindividuell jedoch relativ stabil
- Ein Blutungsrisiko im Rahmen von Operationen ist bei Thrombozytenwerten < 50 G/l zu erwarten, bei einer Thrombozytopenie < 10 G/l besteht die Gefahr für Spontanblutungen
- Bei isolierter Thrombozytopenie im ambulanten Setting sind Hepatopathien, MDS, virale Infekte und Medikamente häufige Ursachen
- Besteht neben der Thrombozytopenie eine hämolytische Anämie und/ oder eine Niereninsuffizienz, muss an eine thrombotische Mikroangiopathie (TTP-HUS) gedacht und der Patient unverzüglich an ein Zentrumsspital zugewiesen werden
- Bei Exposition mit Heparin sollte die Berechnung der Prätest-Wahrscheinlichkeit einer Heparin-induzierten Thrombozytopenie mittels HIT-Score erfolgen und ein Hämostase-Experte kontaktiert werden.
1. Segal, J.B. and A.R. Moliterno, Platelet counts differ by sex, ethnicity, and age in the United States. Ann Epidemiol, 2006. 16(2): p. 123-30.
2. Buckley, M.F., et al., A novel approach to the assessment of variations in the human platelet count. Thromb Haemost, 2000. 83(3): p. 480-4.
3. Reese, J.A., et al., Platelet Counts during Pregnancy. N Engl J Med, 2018. 379(1): p. 32-43.
4. Rousan, T.A., et al., Recurrent acute thrombocytopenia in the hospitalized patient: sepsis, DIC, HIT, or antibiotic-induced thrombocytopenia. Am J Hematol, 2010. 85(1): p. 71-4.
5. Sukati, H., et al., Mapping helper T-cell epitopes on platelet membrane glycoprotein IIIa in chronic autoimmune thrombocytopenic purpura. Blood, 2007. 109(10): p. 4528-38.
6. Lo, G.K., et al., Evaluation of pretest clinical score (4 T’s) for the diagnosis of heparin-induced thrombocytopenia in two clinical settings. J Thromb Haemost, 2006. 4(4): p. 759-65.
der informierte @rzt
- Vol. 9
- Ausgabe 9
- September 2019